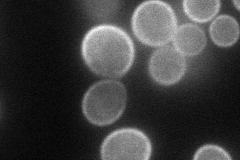
YKL051W

View description
Plasma membrane protein that may act together with or upstream of Stt4p to generate normal levels of the essential phospholipid PI4P, at least partially mediates proper localization of Stt4p to the plasma membrane
Localization:
Intensity:
Fold change:
Significance:
-
C’ GFP library in SD

below threshold13.22 -
N' NOP1pr-GFP in SD
cell periphery75.8713 -
N' TEF2pr-mCherry in SD

cell periphery,vacuole138.782 -
N' NATIVEpr-GFP in SD

cell periphery47.3127 -
N' TEF2pr-VC and Cyto-VN in SD

#N/A0 -
C’ GFP library in SD+DTT

cytosol13.741.03No -
C’ GFP library in SD+H2O2

cytosol14.711.11No -
C’ GFP library in Starvation Media

cytosol14.261.07No -
C’ GFP library on the background of Pup2-DaMP

below threshold -
C’ GFP library on the background of CCT mutant

below threshold15.75361.19126No
